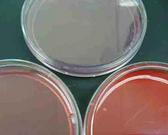

| ||||
Differential & Selective Bacterial Growth Media
Main Page
Virtual Microbiology Classroom of Science Prof Online
Bacterial Growth Media Lecture Materials
These
are the Differential & Selective Bacterial Growth Media Lecture materials of the Virtual Microbiology Classroom. The resources below are used to supplement an actual
16-week college cell biology course.
Page last updated 2/2016
SPO VIRTUAL CLASSROOMS
 | ||||||
SPECIALIZED MEDIA LABORATORY IMAGES
The images linked here directly relate to the lab exercise and are designed to help students review and study that lab material while outside of lab.
You have free access to a large collection of materials used in a college-level introductory microbiology course. The Virtual Microbiology Classroom provides a wide range of free educational resources including PowerPoint Lectures, Study Guides, Review Questions and Practice Test Questions.
How to Interpret MacConkey's Agar (MAC) Specialized
Bacterial Growth Medium
How to Interpret Mannitol Salt Agar (MSA) Specialized
Bacterial Growth Medium
How to Interpret Blood Agar (BAP) Specialized Bacterial Growth Medium
MacConkey's Agar
Quiz & Review:
Do you know MAC from shinola?
The Specialized Bacterial Growth Media Lecture materials include:
- a list of learning objectives
- a PowerPoint lecture
- a homework assignment
- additional required readings
- practice test & review questions
LEARNING OBJECTIVES
These lecture learning objectives are a study guide based on the VMC Differential & Selective Bacterial Growth Media Lecture PowerPoint Show:
- What does it mean for a bacterial growth medium to be selective? Differential?
- Understand the selective and differential aspects of derstand MacConkey's agar (MAC). What information does MAC provide about bacteria growing on this medium?
- Understand the selective and differential aspects of Mannitol Salt agar (MSA). What information does MSA provide about bacteria growing on this medium?
- What type of clinical samples are plated on Blood agar (BAP)? What species are we looking for from a sample plated on BAP?
LECTURE POWERPOINT
Versions of Specialized Bacterial Growth Media PPT:
- Student's Specialized Media PowerPoint Show
- Student's Specialized Media PowerPoint PDF Printout
Printing: The best way for students to print out the PowerPoint Show is to download the PDF version. Select Print, and, when the Print screen comes up, go to the Print Handling options. Under Page Scaling, select "Multiple pages per sheet". Under Pages Per Sheet, select "2". That uses up less paper, placing two slides on each page.
MacConkey's Agar (MAC): Plate on left it growing Gram-negative lactose negative bacterial. Plate on right is growing Gram-negative, lactose positive bacteria.
Click here for more MAC images.
Two plates of Mannitol Salt agar. On left, plate is growtin Staphylococcus aureus, a pathogenic mannitol fermenter. On right, plate is growting non-mannitol fermenter S. epidermidis. Click here for more images of Mannitol Salt Agar.
HOMEWORK ASSIGNMENTS
REQUIRED READINGS
Here is what you need to read, in addition to the PowerPoint, to master this topic. Check Moodle & your textbook for additional readings.
PRACTICE TEST & REVIEW QUESTIONS
These multiple-choice / matching practice test questions and essay review questions designed to help you better understand the material from this lecture.
VIDEOS OF BLOOD AGAR, MANNITOL SALT AGAR & MACCONKEY'S AGAR
 | ||||
MICROBIOLOGY HOMEWORK ASSIGNMENTS